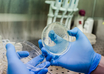

Research shows migraines caused by alterations in metabolite levels
ANI | Nov 28, 2022
Study reveals quarter of former Olympians suffer from osteoarthritis
ANI | Nov 26, 2022
Severe asthma attacks doubled after COVID restrictions lifted
IANS | Nov 26, 2022
Even low drinking during pregnancy alters baby's brain structure
IANS | Nov 26, 2022
Why COVID infection in some causes fatal inflammation, study finds
PTI | Nov 26, 2022
Majority of people with prolonged COVID endure stigma, discrimination: Study
ANI | Nov 25, 2022
Study: CAR T cell therapy reaches beyond cancer
ANI | Nov 25, 2022
Study examines children's mental health during, after COVID pandemic
ANI | Nov 25, 2022
New research reveals relationship between oral bacteria and diseases
ANI | Nov 25, 2022
Most read this week